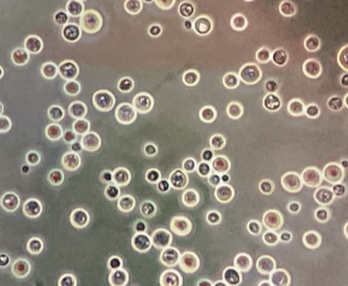

Cuáles son las características biológicas de CRIPTOCOCCUS NEOFORMANS?

Levaduras eséricas ENCAPSULADAS
Replicación por gemación
Saprobio del suelo
Patógeno verdadero (raro) y oportunista (macrófagos alveolares e inmunidad celular)
De qué está compuesta la CÁPSULA de CRIPTOCOCCUS NEOFORMANS?
Polisacáridos
CRIPTOCOCCUS NEOFORMANS es SAPROBIO por ______
Excremento de paloma / árboles de eucalipto
Por qué se dan las MICOSIS SISTÉMICAS por CRIPTOCOCCUS NEOFORMANS?
Se adquiere por inhalación
Diseminación a SNC - SIDA
Se inocula en piel
Cuál es la manifestación clínica más frecuente de CRIPTOCOCCUS NEOFORMANS?

Criptocosis meníngea
Cómo se diagnostica infección por CRIPTOCOCCUS NEOFORMANS?
Tinción con tinta china
Cultivos para el hongo
Antígeno de polisacáridos capsulares
Cómo se trata CRIPTOCOCCUS NEOFORMANS?
Tratamiento por más de 8 semanas
Control de la inmunosupresión


